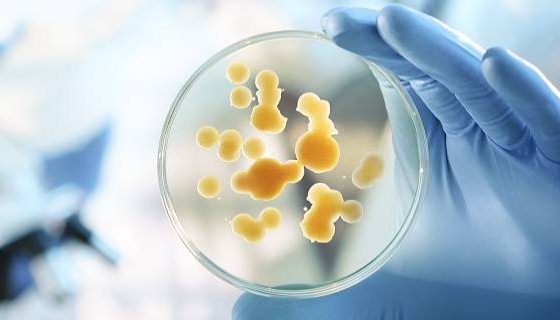
比浊法在环境监测领域的应用方向与技术细节及执行标准！

比浊法在环境监测领域的应用方向与技术细节及执行标准!
比浊法在环境监测领域的核心优势是快速、低成本、可现场、在线监...

实验室生化鉴定方法的准备工作与操作步骤及注意事项!
实验室生化鉴定方法的前期准备工作与操作步骤及注意事项有哪些?

蜡样芽胞杆菌检测之蛋白质毒素结晶试验快速筛选法!
蜡样芽胞杆菌产毒菌株快速初筛方法,核心原理是蜡样芽胞杆菌在适...

改良Y培养基的原理与使用方法及结果判读与质量控制!
改良Y培养基是用于小肠结肠炎耶尔森氏菌选择性分离的固体培养基...

乳糖发酵培养基的实验原理与方法及注意事项与结果判断!
乳糖发酵培养基主要用于鉴别细菌是否能发酵乳糖产酸产气,常用于...

人视网膜色素上皮细胞的体外培养方法及具体操作规程!
人视网膜色素上皮细胞的体外培养方法,根据细胞来源和培养目的,...

微生物实验室节前安全三步操作指南!赶紧收藏起来吧!
随着春节假期临近,对于微生物实验室而言,安全是永远不可放松的...

锰盐营养琼脂的核心原理与使用方法及结果观察与判定!
锰盐营养琼脂是一种选择性、鉴别性培养基,主要用于嗜热脂肪芽孢...

兔乳腺上皮细胞的实验操作要点及应用领域与应用价值!
兔乳腺上皮细胞(RMECs)是研究乳腺生理、病理及生物技术应...